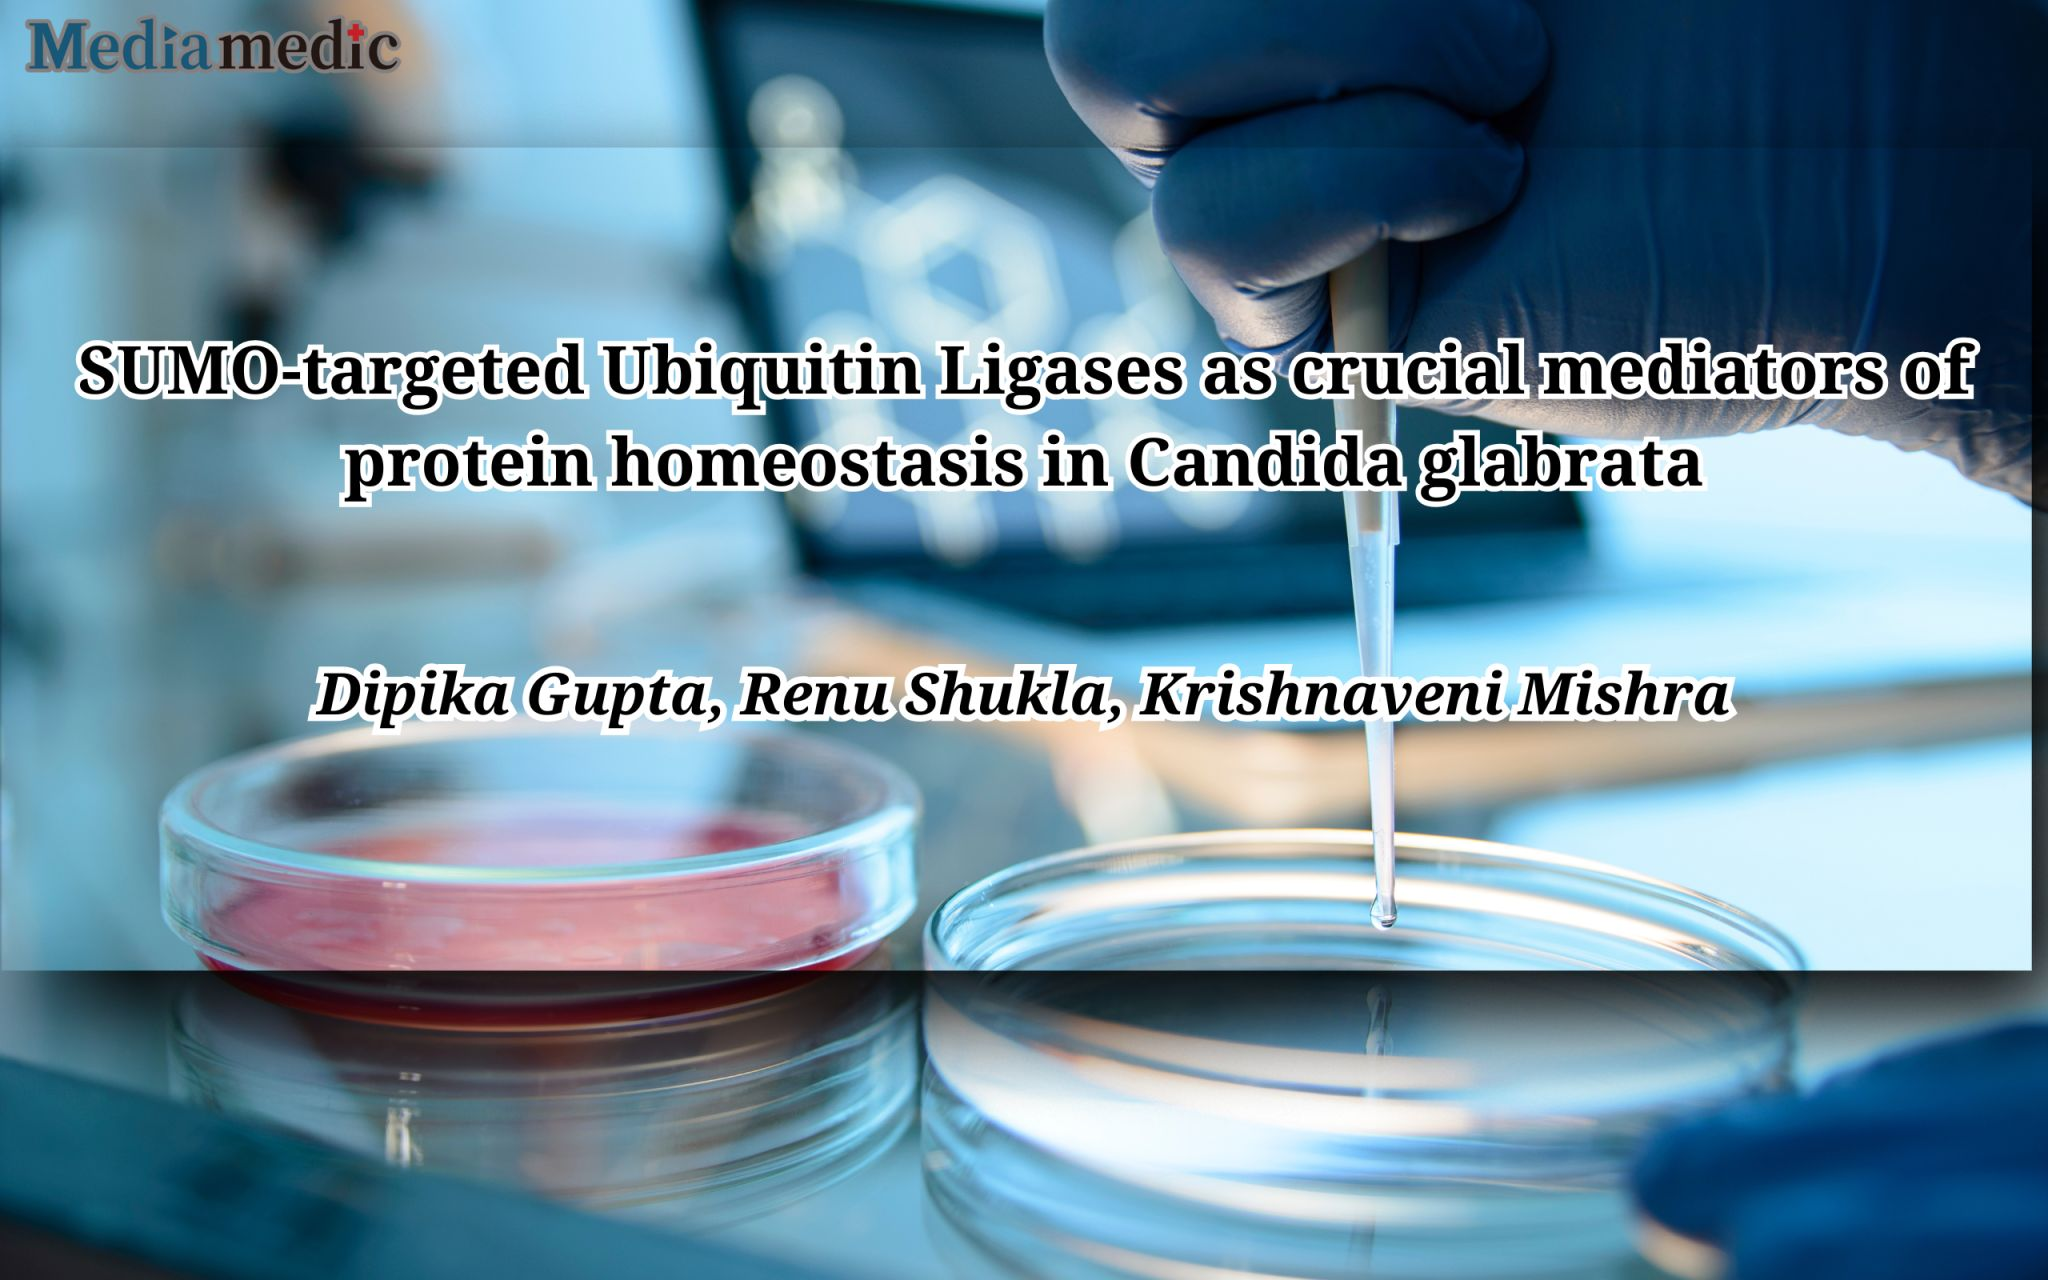

-

Decoding SARS-CoV-2 Omicron Variants: Insights into Cell Entry Dynamics and Antibody Neutralization
A recent study published in PLOS Pathogens explores the mechanisms behind the SARS-CoV-2 Omicron variant’s ability to enter human cells and evade neutralizing antibodies. Researchers identified a key mutation, H655Y, in the spike (S) protein, which significantly alters the virus’s cell entry process and its susceptibility to antibody neutralization.
-

Evaluating Inulin for Gut Pathogen Prevention in ICU Sepsis Patients: A Phase 2 Trial
A recent phase 2 randomized, placebo-controlled trial explored the potential of inulin, a prebiotic fiber, to prevent gut pathogen colonization and infection in patients admitted to the ICU with sepsis. Despite its promising role in preclinical studies, inulin did not significantly alter the gut microbiome or improve clinical outcomes in this high-risk population.
-

Heterogeneity in the Effect of Early Goal-Directed Therapy for Septic Shock: A New Perspective
A recent secondary analysis of the ARISE and ProCESS trials offers valuable insights into the varying effectiveness of Early Goal-Directed Therapy (EGDT) in patients with septic shock. Despite previous randomized controlled trials showing mixed results, this study highlights significant heterogeneity in treatment responses, suggesting that EGDT may benefit some patients while potentially causing harm to…
-

Norovirus: 10 Fascinating Facts You Should Know
With norovirus cases surging across the U.S. this winter, it seems like everyone knows someone who’s been affected. This highly contagious virus is notorious for causing acute gastroenteritis, but there’s much more to it than just a rough couple of days.
-

Understanding Rift Valley Fever Virus Encephalitis: Viral and Host Determinants of Pathogenesis
Rift Valley fever virus (RVFV), a mosquito-borne virus endemic to Africa and the Middle East, poses significant health risks due to its potential to cause severe encephalitis. In this review, Lindsay R. Wilson and Anita K. McElroy from the University of Pittsburgh School of Medicine shed light on the viral and host factors influencing RVFV…
-
Exploring New Avenues for Antifungal Therapies: The Role of SUMO-Targeted Ubiquitin Ligases in Candida glabrata
A recent study published in PLOS Pathogens delves into the intricate mechanisms of protein homeostasis in Candida glabrata, an opportunistic human pathogen known for its resistance to standard antifungal treatments. The research, led by Dipika Gupta, Renu Shukla, and Krishnaveni Mishra from the University of Hyderabad, highlights the critical role of SUMO-targeted ubiquitin ligases (STUbLs)…
-

Comparative Effectiveness of Baricitinib vs. Tocilizumab in Hospitalized COVID-19 Patients: Key Insights from a National Cohort Study
A recent study published in Critical Care Medicine explores the comparative effectiveness of baricitinib and tocilizumab in hospitalized COVID-19 patients. Utilizing data from the National COVID Cohort Collaborative (N3C)—the largest electronic health records database on COVID-19 in the U.S.—this multicenter, retrospective cohort study analyzed outcomes from over 10,000 patients across 75 hospitals.
-

Rectal Temperature: A Game-Changer in Diagnosing Intrapartum Infections
A recent letter published in the American Journal of Obstetrics & Gynecology highlights the critical role of rectal temperature measurement in improving the diagnosis of intrapartum infections. While oral temperature measurements are commonly used, they often underestimate core body temperature, potentially delaying the diagnosis of conditions like chorioamnionitis.
